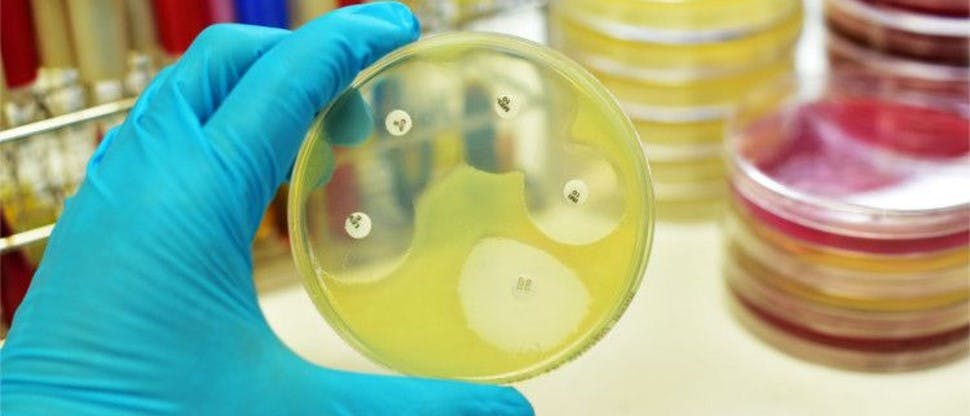
Foto persona sosteniendo muestra de laboratorio

Manejo de la tos

El diagnóstico de tos es una observación clínica obvia
Al igual que con cualquier enfermedad, una recopilación completa y detallada de la historia clínica acompañada de un examen físico adecuado es el aspecto más importante de cualquier evaluación médica. El diagnóstico de tos es una observación clínica obvia. La tos es un síntoma más que un diagnóstico de enfermedad.1
Una tos aguda y subaguda no requiere estudios diagnósticos y debe tratarse de forma sintomática a menos que exista sospecha de una patología insidiosa.1

La mayoría de los casos de tos aguda deben tratarse empíricamente y centrarse en el alivio sintomático
Esto incluye medidas de apoyo de medicamentos de venta libre para la tos como Tesalon.1
Los supresores de la tos se pueden usar para disminuir la tos al atenuar el reflejo de la tos, y los expectorantes o mucolíticos se pueden usar cuando se determina que las secreciones mucosas excesivas son el problema principal para aumentar la eliminación de moco.1
Para la tos productiva, se recomiendan expectorantes como la guaifenesina, mientras que, para la tos seca, los antitusivos como el dextrometorfano son más adecuados.1
Tratamiento antibiótico
Siempre que se sospeche una etiología infecciosa, se debe intentar el cultivo de esputo y la terapia antibiótica adaptada al patógeno.1
En las etiologías infecciosas crónicas de las vías respiratorias superiores, es necesario un tratamiento antibiótico prolongado durante 3 a 6 semanas con un agente adecuadamente seleccionado.1
Ingredientes activos
Descubra más – contra la tos

Recursos educacionales
Los recursos proporcionados aquí le brindarán una comprensión más profunda de la ciencia detrás del tratamiento para combatir síntomas de la salud respiratoria.



